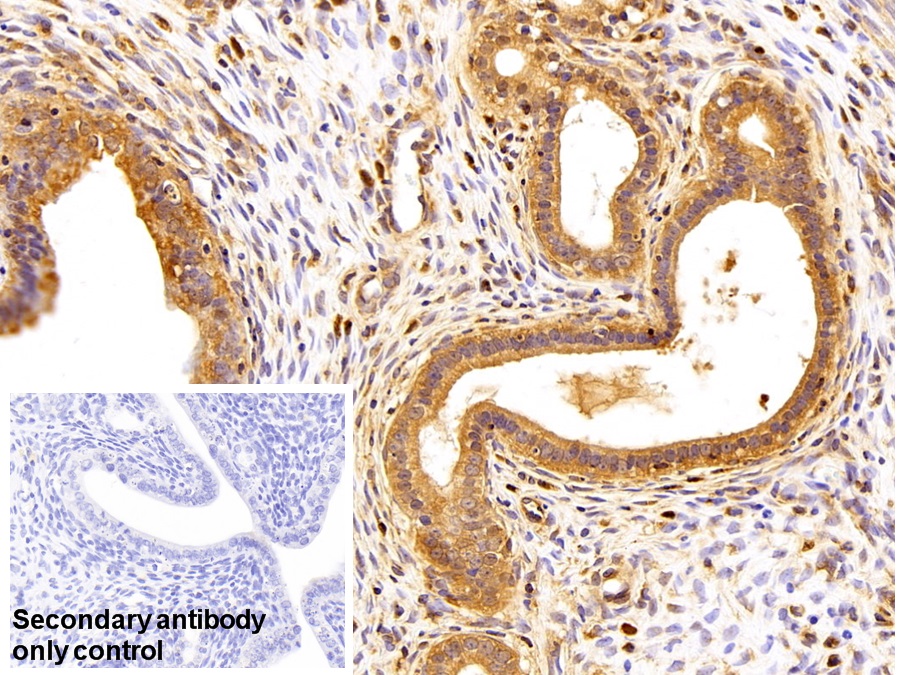

Polyclonal Antibody to Secreted Frizzled Related Protein 4 (SFRP4)
FRP-4; FRPHE; Frizzled protein, human endometrium
- Product No.PAF878Hu02
- Organism SpeciesHomo sapiens (Human) Same name, Different species.
- SourcePolyclonal antibody preparation
- HostRabbit
- Potencyn/a
- Ig Type IgG
- PurificationAntigen-specific affinity chromatography followed by Protein A affinity chromatography
- LabelNone
- Immunogen RPF878Hu02-Recombinant Secreted Frizzled Related Protein 4 (SFRP4)
- Buffer FormulationPBS, pH7.4, containing 0.01% SKL, 1mM DTT, 5% Trehalose and Proclin300.
- TraitsLiquid
- Concentration500µg/mL
- Organism Species MoreRattus norvegicus (Rat), Sus scrofa; Porcine (Pig)
- ApplicationsWB,IHC
If the antibody is used in flow cytometry, please check FCM antibodies. - DownloadInstruction Manual
- UOM 20µl100µl 200µl 1ml 10ml
- FOB
US$ 105
US$ 245
US$ 350
US$ 875
US$ 3500
For more details, please contact local distributors!
SPECIFITY
The antibody is a rabbit polyclonal antibody raised against SFRP4. It has been selected for its ability to recognize SFRP4 in immunohistochemical staining and western blotting.
USAGE
Western blotting: 0.1-2µg/mL;
Immunohistochemistry: 5-20µg/mL;
Immunocytochemistry: 5-20µg/mL;
Optimal working dilutions must be determined by end user.
STORAGE
Store at 4°C for frequent use. Stored at -20°C in a manual defrost freezer for two year without detectable loss of activity. Avoid repeated freeze-thaw cycles.
STABILITY
The thermal stability is described by the loss rate. The loss rate was determined by accelerated thermal degradation test, that is, incubate the protein at 37°C for 48h, and no obvious degradation and precipitation were observed. The loss rate is less than 5% within the expiration date under appropriate storage condition.
GIVEAWAYS
INCREMENT SERVICES
-
 Antibody Labeling Customized Service
Antibody Labeling Customized Service
-
 Protein A/G Purification Column
Protein A/G Purification Column
-
 Staining Solution for Cells and Tissue
Staining Solution for Cells and Tissue
-
 Positive Control for Antibody
Positive Control for Antibody
-
 Tissue/Sections Customized Service
Tissue/Sections Customized Service
-
 Phosphorylated Antibody Customized Service
Phosphorylated Antibody Customized Service
-
 Western Blot (WB) Experiment Service
Western Blot (WB) Experiment Service
-
 Immunohistochemistry (IHC) Experiment Service
Immunohistochemistry (IHC) Experiment Service
-
 Immunocytochemistry (ICC) Experiment Service
Immunocytochemistry (ICC) Experiment Service
-
 Flow Cytometry (FCM) Experiment Service
Flow Cytometry (FCM) Experiment Service
-
 Immunoprecipitation (IP) Experiment Service
Immunoprecipitation (IP) Experiment Service
-
 Immunofluorescence (IF) Experiment Service
Immunofluorescence (IF) Experiment Service
-
 Buffer
Buffer
-
 DAB Chromogen Kit
DAB Chromogen Kit
-
 SABC Kit
SABC Kit
-
 Long-arm Biotin Labeling Kit
Long-arm Biotin Labeling Kit
-
 Real Time PCR Experimental Service
Real Time PCR Experimental Service
| Magazine | Citations |
| Endocrine Journal | Relationship between serum secreted frizzled-related protein 4 levels and the first-phase of glucose-stimulated insulin secretion in individuals with different glucose tolerance PubMed: 26041556 |
| Horm Metab Res. | Secreted Frizzled-Related Protein 4 (SFRP4) is Elevated in Patients with Diabetes Mellitus Pubmed:26882051 |
| Obesity (Silver Spring). | Reduced expression of chemerin in visceral adipose tissue associates with hepatic steatosis in patients with obesity pubmed:27768254 |
| Obesity | Longitudinal Increases in Adiposity Contribute to Worsening Adipokine Profile over Time in Mexican Americans Pubmed:29427376 |
| Novel marker for gestational diabetes patent:US20180059122A1 | |
| British Journal Of Nutrition | A diet high in sugar-sweetened beverage and low in fruits and vegetables is associated with adiposity and a pro-inflammatory adipokine profile Pubmed: 30375290 |
| American Journal of Cancer Research | SFRP4 is a prognostic marker and correlated with Treg cell infiltration in pancreatic ductal adenocarcinoma Pubmed: 30906634 |
| Diabetologia | Effects of long-term exercise on plasma adipokine levels and inflammation-related gene expression in subcutaneous adipose tissue in sedentary dysglycaemic … Pubmed: 31011777 |
| PLoS One | First trimester secreted Frizzled-Related Protein 4 and other adipokine serum concentrations in women developing gestational diabetes mellitus Pubmed: 33206702 |
| Gastric Cancer | SFRP4 drives invasion in gastric cancer and is an early predictor of recurrence 33277667 |
| Diabetology | Early Pregnancy Serum Concentration of Secreted Frizzled-Related Protein 4, Secreted Frizzled-Related Protein 5, and Chemerin in Obese Women Who Develop … |